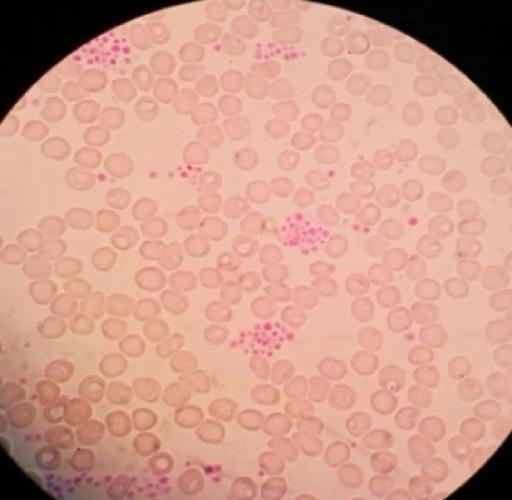
类风湿性关节炎血小板

- 血小板增多
- 血小板减少
这两种情况背后的原因、临床意义和处理方法都完全不同。

(图片来源网络,侵删)
血小板增多
这是RA患者中更常见的一种情况。
为什么会增多?(主要原因)
- 慢性炎症反应: 这是核心原因,RA是一种自身免疫性疾病,体内存在长期的、慢性的炎症状态,炎症因子(如白细胞介素-6, IL-6)会刺激骨髓中的巨核细胞,使其产生和释放更多的血小板,这是一种身体的“急性期反应”,类似于感染或组织损伤后血小板会升高一样,是炎症持续存在的一个标志。
- 疾病活动度的标志: 血小板计数水平与RA的疾病活动度往往呈正相关,也就是说,当关节炎症状(如肿胀、疼痛)越明显,炎症指标(如血沉、C反应蛋白)越高时,血小板的数量也常常越高,医生有时会把它作为评估疾病严重程度的一个参考指标。
临床意义和注意事项
- 并非“坏”现象: 血小板增多本身是身体对炎症的反应,它本身并不直接导致严重的血栓风险(除非数值极高,如 > 1000 x 10⁹/L),看到RA患者血小板轻度至中度升高,医生首先会考虑这是疾病活动度的表现,而不是急于使用降血小板药物。
- 与血栓风险的关系: 虽然RA患者本身就因为慢性炎症状态而比普通人有更高的心血管疾病和血栓风险,但单纯的血小板增多(如 < 800 x 10⁹/L)并不是主要的危险因素,主要的风险还是来自于炎症本身和传统的危险因素(如高血压、糖尿病、吸烟等)。
- 治疗方向: 治疗的关键在于控制RA的原发病,通过使用改善病情抗风湿药(如甲氨蝶呤、来氟米特)、生物制剂或JAK抑制剂等有效控制炎症,随着病情缓解,血小板计数通常会随之下降至正常范围。
血小板减少
这种情况虽然不如增多常见,但一旦发生,就需要更加警惕,因为它可能预示着更严重的问题。
为什么会减少?(可能原因)
- 药物副作用: 这是导致RA患者血小板减少的最常见原因,一些治疗RA的药物可能会抑制骨髓的造血功能,导致包括血小板在内的所有血细胞减少。
- 常见药物: 甲氨蝶呤、来氟米特、硫唑嘌呤 等传统DMARDs都有此可能。
- 监测: 患者在开始使用这些药物后,需要定期复查血常规,监测血小板等指标。
- 自身免疫性破坏: RA的本质是免疫系统紊乱,错误地攻击自身组织,在某些情况下,免疫系统可能会产生针对血小板的抗体,导致血小板被过度破坏,从而减少,这种情况被称为免疫性血小板减少症,在RA患者中,原发性免疫性血小板减少症也可能与RA同时存在或继发于RA。
- Felty综合征: 这是一种RA的严重并发症,表现为“类风湿关节炎 + 脾大 + 中性粒细胞减少”,虽然其主要问题是白细胞(中性粒细胞)减少,但部分患者也可能同时伴有血小板减少,这通常意味着疾病处于非常活跃和严重的状态。
- 骨髓抑制或浸润: 极少数情况下,严重的RA或其长期慢性炎症可能导致骨髓功能衰竭,或者某些血液系统恶性肿瘤(如淋巴瘤)在RA患者中发生率稍高,这些都会抑制血小板生成。
- 其他原因: 感染、肝硬化、弥散性血管内凝血等也可能导致血小板减少,需要鉴别。
临床意义和注意事项
- 出血风险: 血小板减少的主要风险是出血,轻度减少可能没有明显症状;减少到一定程度(< 50 x 10⁹/L)时,容易出现皮肤瘀斑、牙龈出血、鼻出血等;严重减少(< 20 x 10⁹/L)则可能发生内脏出血甚至颅内出血,危及生命。
- 紧急处理: 如果发现血小板显著降低,必须立即就医,医生会迅速寻找原因,并根据严重程度采取紧急措施,例如输注血小板、停用可疑药物、使用升血小板药物(如糖皮质激素、促血小板生成素)等。
- 治疗方向的转变: 如果确定是药物引起的,医生会果断停用或更换该药物,如果是免疫性破坏,则可能需要使用糖皮质激素或其他免疫抑制剂来控制免疫攻击。
总结与建议
| 特征 | 血小板增多 | 血小板减少 |
|---|---|---|
| 常见原因 | 慢性炎症反应(疾病活动度高) | 药物副作用、自身免疫破坏、Felty综合征 |
| 与RA关系 | 常见,是疾病活动度的标志 | 相对少见,但需警惕严重并发症 |
| 主要风险 | 间接增加心血管风险(主要源于炎症本身) | 直接增加出血风险,可能危及生命 |
| 治疗关键 | 积极控制RA原发病(抗风湿治疗) | 立即查找并处理病因(停药、免疫抑制等) |
| 临床意义 | 预后相对较好,随治疗好转 | 可能预示病情严重或药物毒性,需紧急干预 |
给RA患者的建议:
- 定期复查: 严格按照医嘱定期复查血常规,这是监测病情和药物安全性的最重要手段。
- 关注数值变化: 不要只看“高”或“低”,要关注其动态变化趋势,血小板从200升至500,可能提示疾病活动;而从150突然降至80,则需立即警惕。
- 及时沟通: 任何血常规的异常结果,都要及时告知你的风湿免疫科医生,由医生来判断其临床意义和下一步的处理方案,切勿自行判断或停药。
- 留意症状: 如果出现异常出血或瘀斑,如刷牙出血、皮肤无故出现大片青紫、流鼻血不止等,应立即就医。
类风湿性关节炎与血小板的关系复杂多变,需要结合患者的具体病情、用药情况和临床症状进行综合判断,在专业医生的指导下进行规范治疗和监测,是保障安全和健康的关键。
(图片来源网络,侵删)

(图片来源网络,侵删)




